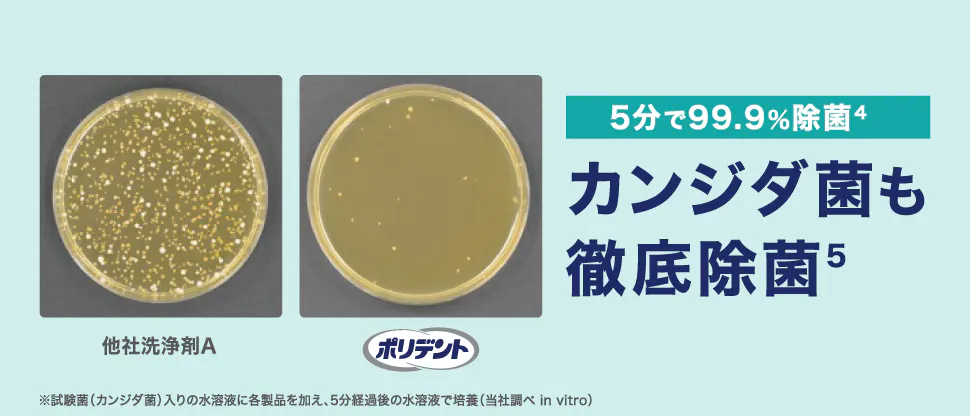
ガンジダ菌も徹底除菌

ポリデント 義歯洗浄剤

義歯洗浄剤を毎日使用することで、ブラッシングのみの場合と比較して義歯表面の汚れ(バイオフィルム)を大幅に減らせることを示しています。
特に、洗浄剤とブラッシングを7日間毎日併用した群では、より高い清浄度を維持できることが視覚的に示されています⁶。
in vitro 試験、1群と3群の比較 p<0.0001
緑色はバイオフィルムの増殖を示す

水浸漬に比べ、ポリデントは3分時点から高いステイン除去率を示し、15分でも優位性を維持しています。時間延長で双方とも除去率は上がりますが、いずれの時間でもポリデントが大きく上回ることが示されています7。
患者さん用リーフレットをご用意しております

患者さん用の指導リーフレットを活用いただくことで義歯をはずした後のお手入れ方法の指導がしやすくなります。
リーフレットは、こちらよりダウンロードいただけます。
もしくは、サンプル依頼よりご注文が可能です。

ポリデントプレミアム部分入れ歯用
ダブル洗浄部分入れ歯用ポリデントの2倍の洗浄成分が発生*。強力発泡で徹底洗浄!3分で99.99%除菌4

泡の力で隅々まで洗浄・消臭!5分で99.9%除菌5。発泡!強化8!